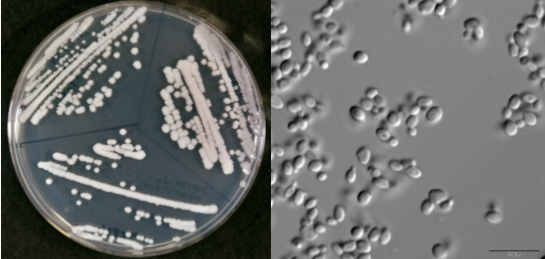

건강한생활
🦠 “피부에 딱 들러붙어” 전 세계 불어닥친 ‘이 곰팡이’ 주의보… 일으키는 증상 봤더니?
꿈나래-
2026. 1. 7. 16:38

“피부에 딱 들러붙어” 전 세계 확산 중인 ‘이 곰팡이’ 주의보… 어떤 증상을 일으킬까?
요즘 의료계에서 가장 긴장하는 이름 중 하나, 바로 **칸디다 아우리스(Candida auris)**입니다.
이 곰팡이는 단순 무좀이나 피부 트러블 수준이 아니라, 병원 감염을 일으키는 고위험 진균으로 전 세계에 확산 중입니다.
별명이 괜히 붙은 게 아닙니다.
👉 “피부에 착 붙어 잘 안 떨어지는 곰팡이”
🦠 왜 이렇게 위험할까?
칸디다 아우리스의 전략은 꽤 교활합니다.
- 피부·침구·의료기기 표면에 오래 생존
- 일반 소독제에 잘 안 죽음
- 여러 항진균제에 내성
- 사람 간 접촉으로 전파
즉, 끈질기고, 숨어 있고, 잘 안 잡히는 곰팡이입니다.
🚨 어떤 증상을 일으키나?
문제는 증상이 애매하거나 갑자기 악화된다는 점입니다.
초기·경미
- 발열, 오한 (항생제 써도 안 떨어짐)
- 피부 발진, 가려움
- 귀 통증, 분비물 (처음엔 단순 외이도염처럼 보임)
중증 진행 시
- 혈류 감염(패혈증)
- 호흡곤란, 저혈압
- 장기부전
👉 특히 면역력이 약한 사람에게 치명적입니다.
⚠️ 고위험군은?
- 중환자실 입원 환자
- 고령자
- 당뇨·암·장기이식 환자
- 장기 항생제·스테로이드 사용 중인 경우
건강한 사람은 대부분 큰 문제 없이 지나가지만,
**병원 안에서는 ‘조용한 폭탄’**이 됩니다.
🧼 개인이 할 수 있는 예방법
- 병원 방문 후 손 씻기 철저
- 피부 상처 방치하지 않기
- 링거·카테터 사용 중 발열 지속되면 즉시 알리기
- 보호자도 위생수칙 준수 (침상·손 접촉 주의)
📌 한 줄 요약
**칸디다 아우리스는 ‘무좀의 친척’이 아니라
‘병원 감염계의 끝판왕’**입니다.
가렵다고 가볍게 볼 곰팡이가 아닙니다.
특히 병원에 오래 머무는 분이라면,
발열이 이상하다 싶을 때 바로 의심하는 게 생명을 지킬 수 있습니다.
반응형
LIST